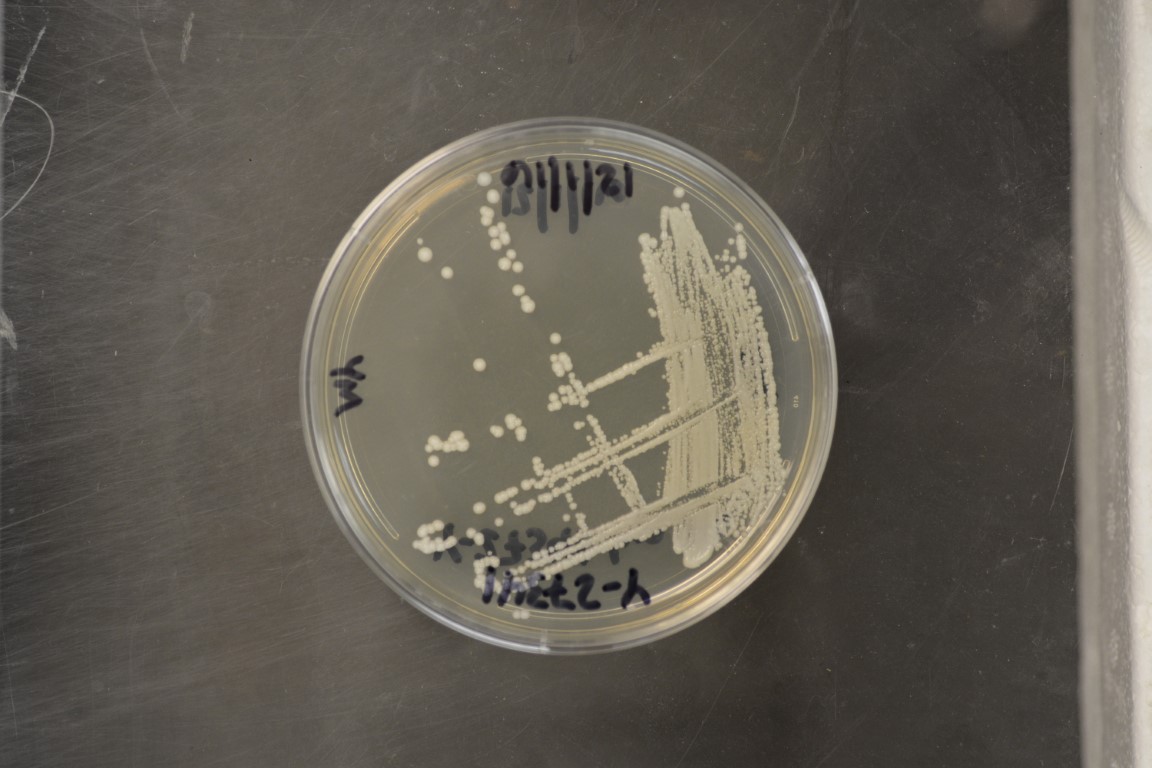

Saccharomyces mikatae
NRRL Y-27341(Type Strain)
Accession numbers in other collections:AS 2.2407=ATCC MYA-4448=CBS 8839=DBVPG 7991=IFO 1815=IFO 1815-2A=MUCL 46199=Naumov 1815-2A=NCYC 2888
Source:G.I.Naumov,State Institite for Genetics&Selection of Industrial Microorganisms,Russia
Isolated from(substrate):SL,soil
Substrate location:Japan
Genetic info:ROBNETT PCR#A373;0 diff.D1/D2,18s,ITS,EF,LSC,and LSD with Y-27342;1 diff.MS with Y-27342;11 diff.COII with Y-27342.GenBank:D1/D2(AF398479),SSU(AY046225),ITS(AY046149).
Growth media:Yeast Extract-Malt Extract-Peptone-Glucose(YM for yeasts)(number 6)
Optimum growth temperature:25C
Strain images:
NRRL_Y-27341_6.JPG

Comments:Homothallic monosporic culture of IFO 1815